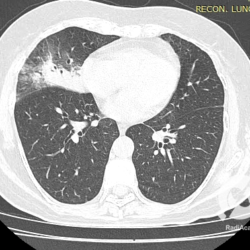

Pneumonia
Pneumonia, de uma maneira simples, é um processo infeccioso agudo do pulmão, sendo que algumas infecções eventualmente podem se arrastar, tornando-se crônicas. Por vezes o termo pneumonia é usado para denominar condições inflamatórias não infecciosas, enfim se a gente quiser pode complicar, mas no momento, vamos focar no mais frequente: infecções pulmonares.
Os agentes etiológicos infecciosos são variados (bactérias, vírus, fungos, parasitas…), mas o que ocorre nos pulmões durante uma infecção por qualquer tipo de agente é a substituição do ar alveolar por secreção (pus, muco, eventualmente sangue ou necrose…) e com isso a manifestação radiográfica vai ser a mesma já que todas estas secreções apresentam a mesma densidade radiográfica: partes moles.
E o nome dado a esta alteração radiográfica que corresponde à substituição do ar alveolar por líquido é a consolidação alveolar.
Uma consolidação alveolar é, por definição, uma opacidade (imagem densa, branquinha) homogênea ou às vezes heterogênea (pela presença de calcificações ou cavidades), de limites mal definidos, exceto quando toca a pleura da parede ou das cissuras pulmonares. É um termo usado tanto em radiografia, como em tomografia computadorizada. Na tomografia, um outro termo é usado: vidro fosco, que é uma opacidade (branquinha mas não tanto como a consolidação), que borra o pulmão mas deixa ver os vasos de permeio (igual bigode de adolescente: dá pra ver todo o fundo).
Nós vamos mostrar aqui um pequeno apanhado de pneumonias de variados agentes, em diversos segmentos e lobos pulmonares, com extensões variadas. O objetivo é identificar o padrão radiológico de consolidação alveolar e não determinar o agente infeccioso, isso vai ser assunto para mais adiante. Aliás já antecipo que é fundamental saber localizar a lesão, porque alguns destes bichos gostam de determinados segmentos, alguns tumores também têm as suas preferências, então localização é fundamental. Se localização não fosse importante, um apartamento na beira do mar sairia o mesmo preço de um apartamento de frente pra BR-101, concordam?
Seguem alguns dos nossos casos de pneumonia para vocês treinarem os olhos e não se apavorarem nos plantões.